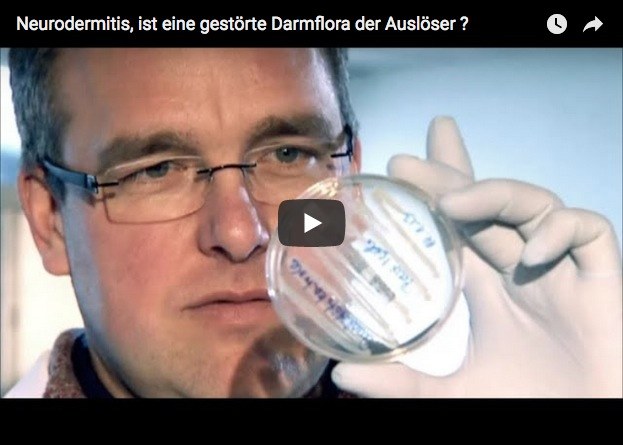
Ist eine gestörte Darmflora der Auslöser

Helfen Probiotika gegen Neurodermitis?
Obwohl die aktuelle Studienlage, die viele Betroffenen bewegende Frage, ob die Einnahme von Probiotika in der Schwangerschaft und später Kleinkinder vor Neurodermitis schützen kann, durchaus positiv bewertet werden darf, bleiben noch viele Fragen dazu offen.
Neurodermitis, auch als atopische Dermatitis oder atopisches Ekzem bezeichnet geht mit trockener rissiger oder nässender Haut, qualvollem Juckreiz, und vielfach auch häufig auftretenden Hautinfektionen einher. Die Zahl der Betroffenen schwankt zwischen weltweit fünf und bis zu 20 Prozent. Die in Schüben verlaufende Krankheit ist nicht ansteckend, betrifft jedoch vielfach ab dem frühen Kleinkindalter. Es ist nur verständlich, dass Eltern, die selbst an Neurodermitis leiden, ihren Kindern den Leidensweg ersparen möchten. Vorbeugende Maßnahmen wie Probiotika, aber auch alternative Behandlungsmethoden werden nur zu gerne ausprobiert.
Probiotika (pro = für, Bios = Leben) sind lebensfähigen Mikroorganismen, die z.B. in Milchprodukte vorkommen, helfen bei der Verdauung und sorgen auch für ein gesundes Immunsystem. Sie siedeln im Darm und werden in aller Regel über den Mund aufgenommen. Probiotika können in der Apotheke in Kapselform gekauft werden.
Wie die veröffentlichten Studien zeigen, können Probiotika möglicherweise Schwangere, aber auch Säuglinge/Kleinkinder vor Neurodermitis schützen, vor allem wenn die werdenden Mütter gemischte Probiotika-Stämme zur Vorbeugung einnehmen. Nicht geklärt und daher noch zu erforschen ist, welche der zahlreichen probiotischen Stämme, wie u.a. Laktobazillen und Bifidobakterien, hierbei am wirksamsten sind und welche Menge davon sinnvoll wirkt. Abgeraten wird von der Einnahme bei einem geschwächten Immunsystem oder bei Frühchen.
Neurodermitis - Auslöser noch unbekannt
Warum man an einer Neurodermitis erkranken kann, ist heute noch immer nicht aufschlussreich geklärt. Vermutlich handelt es sich einerseits um eine erbliche Veranlagung verbunden mit zahlreichen, individuell unterschiedlichen Auslösern. An Neurodermitis erkrankte Eltern geben die Krankheit oft an ihre Kinder weiter. Ebenso können verschiedene Nahrungsmittel, Pollen und Haustiere, aber ebenso Hitze, Kosmetika und/oder Waschmittel sowie Stress und psychische Belastungen Neurodermitis auslösen oder verstärken. Allergische Erkrankung, wie Asthma oder Heuschnupfen werden ebenso häufig bei Betroffenen beobachtet.
Da die Therapie mit Juckreiz-stillenden Medikamenten und rückfettenden Salben ist nicht immer erfolgreich. Die Krankheit begleitet Betroffene oft lebenslang.